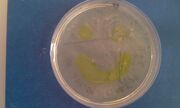

Uploads by Kirill Shkura
From OpenWetWare
Jump to navigationJump to search
This special page shows all uploaded files.
| Date | Name | Thumbnail | Size | Description |
|---|---|---|---|---|
| 12:46, 2 September 2010 | IMAG0315.jpg (file) | |
470 KB | |
| 12:33, 2 September 2010 | IMAG0322.jpg (file) |  |
474 KB | |
| 12:33, 2 September 2010 | IMAG0313.jpg (file) |  |
565 KB | |
| 12:32, 2 September 2010 | IMAG0310.jpg (file) |  |
381 KB | |
| 13:48, 24 August 2010 | LacI testing construct.JPG (file) |  |
28 KB | |
| 13:47, 24 August 2010 | K02 and oligos.JPG (file) |  |
23 KB | |
| 13:45, 24 August 2010 | K70 n K64.JPG (file) |  |
20 KB | |
| 10:58, 24 August 2010 | AmyE assembly Stategy.JPG (file) |  |
72 KB | AmyE Assembly Strategy |